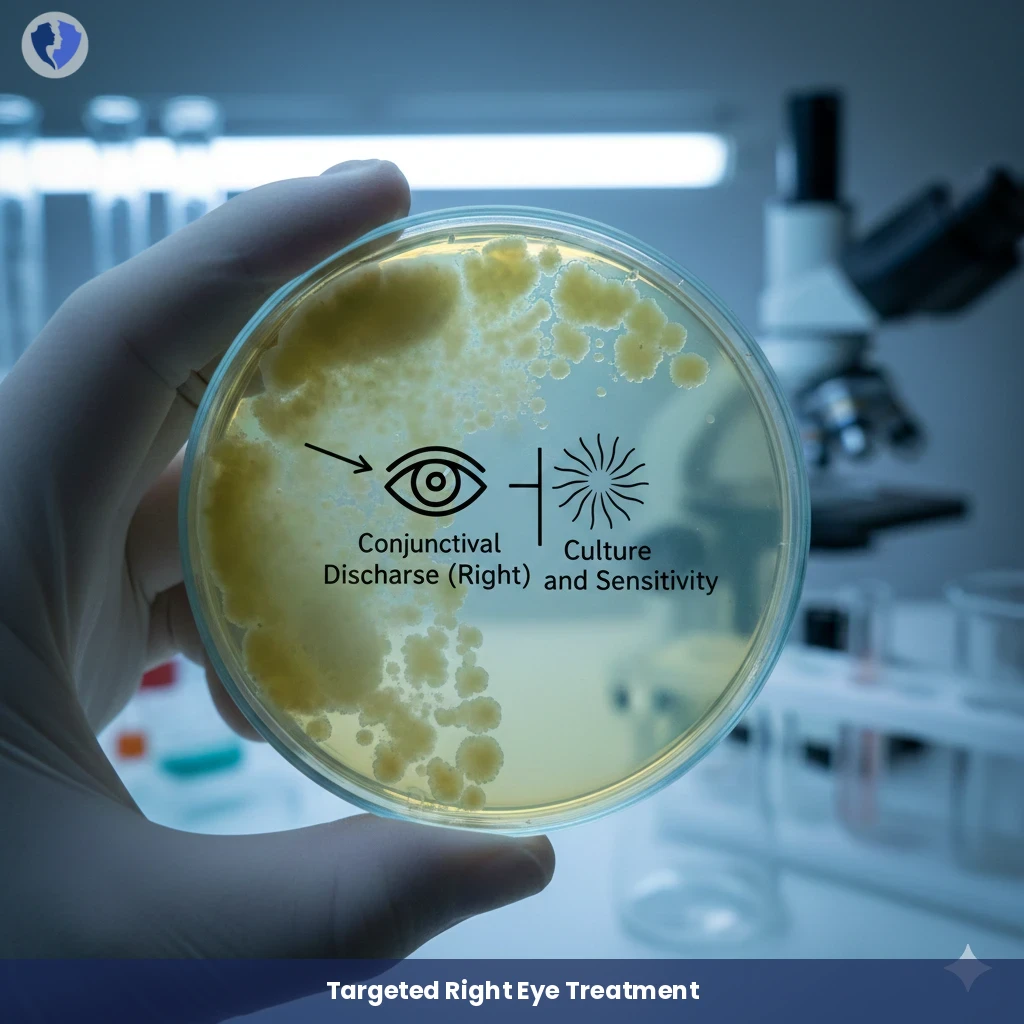
Right Eye Conjunctival Culture

Service Details
Right Eye Conjunctival Culture
A microbiological examination is performed on a swab sample of purulent or mucous discharge from the conjunctiva (the thin membrane lining the eyelid and the inside of the eye) of the right eye. The aim is to isolate and identify the bacteria or fungi causing the infection (bacterial or fungal conjunctivitis), followed by antibiotic susceptibility testing to determine the appropriate antimicrobial agents and guide precise and effective treatment.